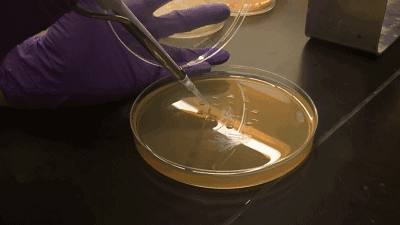

由于人体恒定的体温给许多病原体提供可靠的“居住”条件,所以在人类历史上出现过许多可怕的传染病,甚至人类向全球迁徙的驱动因素都是这些传染病。
在新中国成立之初,由于人口的爆炸性增长,同时卫生条件有限,这给传染病提供了良好的传播条件,所以在当时,许多人类历史上最古老、可怕的传染病都开始肆虐,其中就包括沙眼——人类最普遍致盲的眼部疾病之一。
据信,当时在卫生条件较差的农村得病率可以达到90%以上,而即便是卫生条件很好的上海,沙眼的得病率也是达到了50%左右,所以当时流传着“十人九沙”的说法。

沙眼最容易感染的群体是儿童,在我的印象中,小时候只要眼睛稍微红肿一下,家里人就会惊恐地以为我得了沙眼。
我记得当时许多人认为沙眼可以通过互相对视传播,所以眼睛红肿的人就会被当作异类,没人敢跟他对视;更有趣的是,大家还都认为拔掉眼睫毛就可以治疗沙眼,所以眼睛一红起来就疯狂拔眼睫毛。

沙眼给几代人留下了深刻印象,不过在2014年的时候,中国就对外宣布达到了世界卫生组织根治致盲性沙眼的要求,而到了今年3月份世界卫生组织已确认中国消除沙眼。
那么,沙眼到底是什么样的疾病,中国又是如何成功清除沙眼的呢?

沙眼,图源:Flickr
沙眼:人类史上最古老的传染病之一
虽然中国已经完全清除沙眼,但是在世界范围内,沙眼至今还在肆虐,目前至少还有1.57亿人生活在沙眼风险地区,其中绝大部分都是非洲国家。
大约还有190万人因为沙眼而致盲或者视力下降,总的来说,目前沙眼依然是全世界致盲的主要原因之一。
实际上,沙眼是已知人类最古老的传染病之一,目前科学家发现的最古老的沙眼病例可以追溯到10000年前——澳大利亚一个原住民的眼部骨骼上有明显的沙眼留下的后遗症特征。
沙眼患者的眼皮内部会出现滤泡,然后患者的眼睛会像进了沙子一样难受,这可能就是“沙眼”叫法的由来吧。

图源:Getty Images
一个人一旦得了沙眼,基本上很难自行痊愈,沙眼会伴随患者一生,无时无刻给患者眼睛带来痛苦,直到完全失眠也不会罢休。
在感染的初期,眼部会有较强烈的反应,眼睛会充血且伴有分泌物,同时会很痛、很痒。
不过,在急性症状之后症状就会减轻,这是因为形成了瘢痕组织,许多人可能以为是痊愈了,其实只是进入了一个慢性瘢痕性过程。

在瘢痕性过程中会出现一些永久性的伤害,其中最明显的就是眼睑内翻,沙眼致盲的原因就是眼睑内翻导致眼睫毛刮到眼角膜,最终导致眼角膜受损——这是一个不可逆的失明过程。
一般人每天需要眨眼15000多次,对于沙眼患者来说,每一次眨眼都十分痛苦,都在磨损自己的眼角膜。
可能也正是因为沙眼患者的睫毛老刮到眼角膜带来疼痛,所以我们许多人会认为拔掉眼睫毛可以治疗沙眼(我看到其它国家也都有这样的说法),毕竟没有眼睫毛确实可以减轻这种痛苦。
其实,除了拔掉眼睫毛外,还有很多奇怪的沙眼 “民间疗法”,在中国一些地区,医生甚至会用刀伸进眼睛去刮掉沙眼的滤泡,以试图治疗沙眼(想想都可怕)。

出现这些奇怪的沙眼治疗方案的原因很简单,当时的人们根本不知道是什么导致了沙眼。
而第一个分离出沙眼病原体的是中国的科学家——汤飞凡,而且是在科研条件非常恶劣的情况下完成这一壮举的,在当时真的非常了不起。
沙眼病原体
在20世纪初,科学界其实是非常急功近利的,因为当时的世界就像一个刚刚被打开的“魔盒”,有许多颠覆性的事实等着人们去发现。
许多科研人员生怕自己辛苦研究的项目被别人抢先发表,于是会在还没有充分数据的时候就直接发表论文,所以当时出了很多乌龙。
像沙眼这种世界性的疾病,研究的人很多,竞争非常激烈,当时日本的科研人员——野口英世就在没有太多事实支撑的情况下宣布自己团队已经分离出沙眼病原体。

图:前排右三是汤飞凡
汤飞凡觉得野口英世的方法无法得到沙眼病原体,他个人以1929年春回到国内后,第一件事就是按照野口英世的方法分离了沙眼病原体。
然后,他将分离出来的“病原体”用猴子做实验,结果猴子在7个月后依然没有出现沙眼症状,所以他断定日本科学家的方法根本没法分离出沙眼病原体。
然而,当时中国的科研能力根本不被世界认可,否定日本科学家的做法一下子把汤飞凡推到了风口浪尖。
即便在科学界受到了许多非议,同时当时的中国局势也十分不稳定,但这些都没有让汤飞凡停止对沙眼病原体的研究。
直到1955年,在经历了7次失败之后,汤飞凡和他的团队总算在第8次实验中成功分离出一株“病毒”(当时以为是病毒),并命名为TE8。

图:沙眼衣原体
现在我们知道沙眼的病原体既不是病毒,也不是细菌,它是衣原体,被沙眼患者瞪一眼,衣原体不会飞到别人的眼睛,拔睫毛也无法清除衣原体。
衣原体和细菌一样也是原核生物,但是相较于细菌它无法自行合成ATP,其生命过程的所有能量都由宿主细胞提供。
另一面,衣原体的大小,以及生存模式都更像是病毒,但是相较于病毒,衣原体又拥有DNA和RNA两种核酸、以及一个近似细胞壁的膜。
由于衣原体在结构上更像细菌,所以在抗生素已经普及的当时,这种疾病还是很好治疗的,只要使用广谱抗生素就能治好。
另外,知道了沙眼的致病因素之后,阻断沙眼传播方案也就非常明显了,只要勤洗手、少揉眼,毛巾这些卫生用品分开使用就好了。
所以在之后的几年里,沙眼的得病率就下降得非常明显,到了21世纪,沙眼已经基本从中国消失了。
最后
其实,在汤飞凡质疑日本科学家之后,世界上有许多科学团队都致力于寻找新方法分离出沙眼病原体,但都一无所获。
汤飞凡是第一个分离出衣原体的科学家,所以他是世界公认的“衣原体之父”。
事实上,在得到沙眼衣原体之后,他还拿自己的眼睛做了实验,以此得到最宝贵的临床数据。
另外,作为中国最早的微生物研究人员,汤飞凡的成就远不只是沙眼衣原体,他还是中国的“疫苗之父”。
我们前面提到过,他在1929年回国后的第一件事就是着手沙眼的研究,但直到1955年才得到沙眼衣原体,其实中间的这些时间,他还成功分离出青霉素,以及牛痘疫苗,都是中国首次。
在汤飞凡的推动下,新中国的防疫“装备”从一无所有,到拥有至关重要的青霉素,以及各种疫苗,让可怕的天花、麻疹、狂犬病等可怕疾病提前在中国消失。